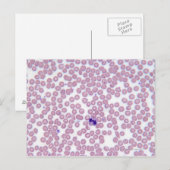
Malariablutzellen Postkarte (Vorne/Hinten)
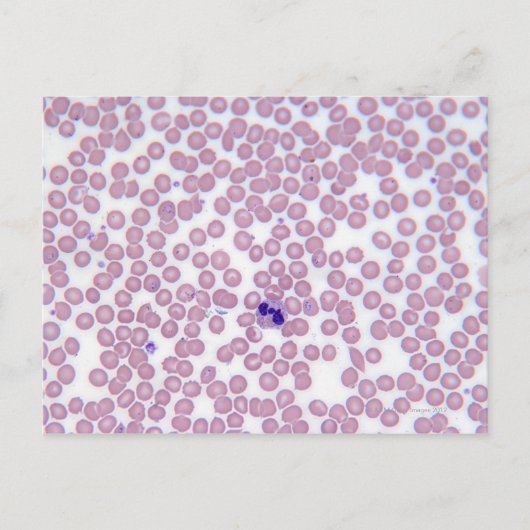
Malariablutzellen Postkarte (Vorderseite)

Über Postcards
Verkauft von
Über dieses Design
Malariablutzellen Postkarte
Malariische Blutzellen | "Michael J. Klein, M.D." | AssetID: 142021985
Automatische Übersetzung
Kundenrezensionen
4.8 von 5 Sternen Bewertung374 Bewertungen insgesamt
374 Bewertungen
Bewertungen für ähnliche Produkte
5 von 5 Sternen Bewertung
Von S.25. Oktober 2020 • Geprüfter Kauf
Postkarte, Größe: Standard Postkarte, Papier: Signature-Matt, Umschläge: Keine
Bewertungsprogramm bei Zazzle
Als langjährige Postcrosserin suche ich immer nach neuen, exklusiven Postkarten und werde bei Zazzle immer fündig! Bis auf eine Karte (Kate und William) waren alle Drucke immer top!
5 von 5 Sternen Bewertung
Von Corinna S.8. Dezember 2012 • Geprüfter Kauf
Postkarte, Größe: Standard Postkarte, Papier: Signature-Matt, Umschläge: Keine
Creator Bewertung
dieses produkt hat meine erwartungen voll entsprochen.würde ich immer wieder kaufen.der druck ist erstklassig. die druckqualität ist super auch das design erstklassig.
4 von 5 Sternen Bewertung
Von Vera P.29. Dezember 2020 • Geprüfter Kauf
Postkarte, Größe: Standard Postkarte, Papier: Signature-Matt, Umschläge: Keine
Bewertungsprogramm bei Zazzle
Auch hier ist es leider passiert, dass die Rückseite verkehrt herum bedruckt ist. Das ist besonders blöd, wenn es sich um einen Text handelt. Dieser Engel ist ja sehr filigran und fein. Dennoch strahlen sogar die feinen Linien auf der Karte. Man kann sich sogar in das Gesicht einfinden - was beim Beten für viele wichtig ist.
Tags
Andere Informationen
Produkt ID: 239656168823798443
Gemacht am: 29.10.2012, 15:43
Bewertung: G
Zuletzt angesehene Produkte